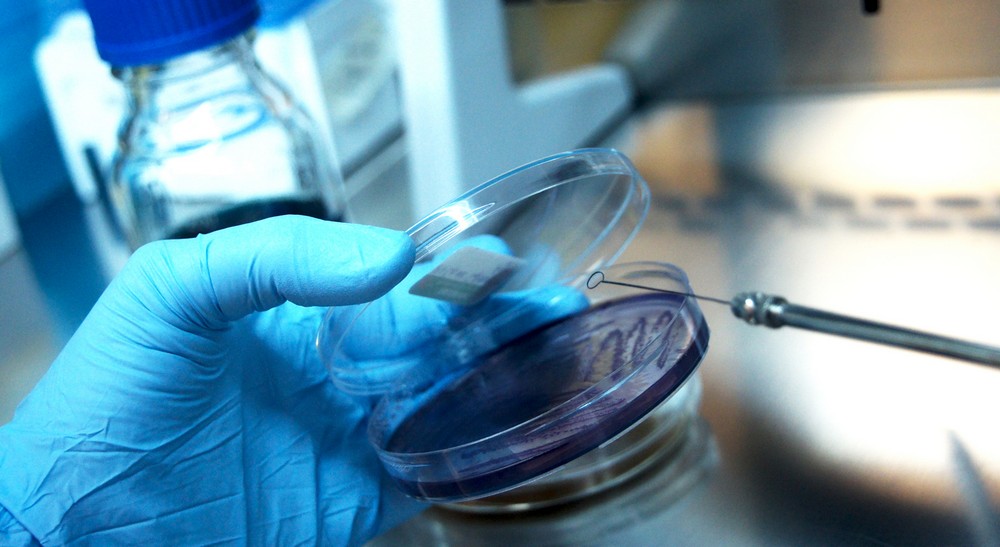

Doğa bilimlerinde abiyogenez, yaşamın kökeni sorusu, yeryüzünde yaşamın canlı olmayandan nasıl gelişebildiğinin araştırılmasıdır. Uzun yıllar canlıların çamur, çürüyen organik materyal veya sıcak sulardan kendiliğinden oluştuğu spontan generasyon = abiyogenez = kendiliğinden varoluş görüşü yaygındı. Havada bırakılmış etlerde kurtçukların oluşması bu görüşün en önemli kanıtlarından biri olarak kabul ediliyordu. F. Redi, canlıların bir önceki canlıdan meydana geldiğini deneysel olarak gösteren ilk bilim adamıdır. Redi, deneyinde ilk başta sekiz kavanozun içine et koymuş ve dördünün ağzını kapatıp, diğer dördünü açık bırakmıştır. Deneyin sonucunda sadece ağzı açık olan kavanozların yani sineklerin yumurtalarını bırakabileceği kavanozların içinde kurtçukların oluştuğunu görmüştür. Redi’nin karşıtları, yani abiyogenezi savunanlar, ise dört kavanozun hava almadığı için larvaların oluşmadığını savunmuşlardır. Redi, bunun üzerine o dört kavanozun ağzını sadece hava alabilecek kadar küçük gözenekleri bulunan bezlerle kapatıp deneyi tekrarlamış ve yine larvaların oluşmadığını gözlemlemiştir. Redi’nin bu deneyi biyogenez’i destekler nitelikte bir deney olmuştur. Böylece abiyogenez teorisini ilk kez F. Redi çürütmüştür.
Biyogenez, başka yaşam biçimleri doğuran yaşam biçimi işleyişidir. Örneğin bir örümcek yumurtlayarak başka bir örümcek meydana getirir. Terim aynı zamanda, yaşamın uygun koşullar altında canlı olmayandan üreyebileceğini, henüz bu koşullar bir bilinmez olarak kalsa da, savunan abiyogenez varsayımının tersine, bir canlı maddenin sadece canlı bir maddeden üreyebileceğini iddia eden varsayım için de kullanılmaktadır.
L. Pasteur’e kadar birçok bilim adamı abiyogenez teorisini test eden deneyler yapmıştır. Pasteur, abiyogenez teorisine şiddetle karşı çıkan bir bilim adamı olarak mikroorganizmaların havada ve yüzeylerde bulunabileceğini ve uygun şartlar bulduklarında çoğalacaklarını deneysel olarak göstermiş ve bu teoriyi tamamıyla yıkmıştır. Spontan generasyon (abiyogenez) teorisinin yıkılması yerini biyogenez teorisine bırakmıştır yani bir canlının yine başka bir canlıdan meydana gelebileceği görüşü kanıtlanmış oldu.